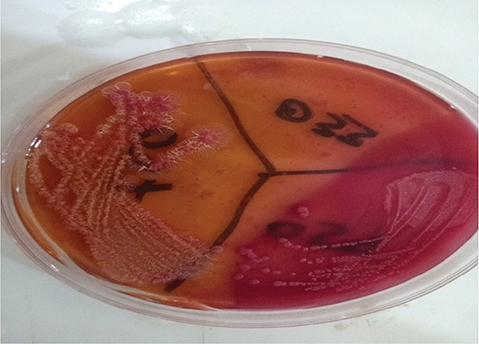
Fig 1

ORIGINAL ARTICLE
Olufemi O. Aluko1*, Abisola M. Ojebola1, Adediwura O. Okeleye1, Mayowa W. Olaoye1, Samuel O. Onyekweli1, Olusegun T. Afolabi1 and Olaniran Olarinde2
1Department of Community Health, Obafemi Awolowo University, Ile-Ife, Nigeria; 2Department of Medical Microbiology, Obafemi Awolowo University, Ile-Ife, Nigeria
Healthcare workers (HCWs) are the first responders in healthcare facilities and are disproportionately exposed to infectious diseases. Facemask is a potential barrier to containing the spread of infectious droplets, aerosols and contaminated surfaces. This study isolated the bacterial contamination associated with using facemasks amongst HCWs interacting with patients. This research utilised the descriptive cross-sectional study design to obtain data from 161 HCWs selected through a multi-stage sampling technique. 2 mm × 2 mm of nose and mouth regions of facemasks were aseptically collected and cultured using standard methods. Antibiotic sensitivity tests were done using standard diagnostic kits. Most (61.5%) of HCWs were females, and 70.8% were between 20 and 39 years. 39.1%, 31.7%, 14.3% and 9.9% were nurses, doctors, health attendants and laboratory technicians, respectively. In this study, 62.7% and 49.7% had a good perception of WHO guidelines for using and removing facemasks, respectively. 74.5% of HCWs volunteered their used facemasks, and 25.6% had growth when cultured. The predominant bacteria isolates were Enterobacter agglomerans (62.5%), Proteus stuarti (28.1%) and Morganella morganii (9.4%) and 96.9% resistant to Augmentin and Ceftazidime, 93.8% were resistant to Cefuroxime and 87.5% were resistant to Cefixime with the highest zones of inhibition to Ofloxacin. Most HCWs have good knowledge but fail to practice the appropriate guidelines for facemask use. Facemasks harbour nosocomial organisms, and many of them are resistant to common antibiotics.
Keywords: facemasks; drug-resistant bacteria; antimicrobial sensitivity tests; COVID-19; healthcare workers
Citation: Int J Infect Control 2025, 21: 23783 – http://dx.doi.org/10.3396/ijic.v21.23783
Copyright: © 2025 Olufemi O. Aluko et al. This is an Open Access article distributed under the terms of the Creative Commons Attribution 4.0 International License (http://creativecommons.org/licenses/by/4.0/), allowing third parties to copy and redistribute the material in any medium or format and to remix, transform, and build upon the material for any purpose, even commercially, provided the original work is properly cited and states its license.
Received: 29 January 2024; Accepted: 10 March 2025; Published: 28 April 2025.
Competing interests and funding: This research received no specific grant from funding agencies in the public, commercial or not-for-profit sectors. The authors report no conflict of interest.
*Olufemi O. Aluko, Department of Community Health, Obafemi Awolowo University. Email: ooaluko@oauife.edu.ng; ooaluko@gmail.com
Facemasks are simple and effective means of interrupting the transmission of infectious diseases, including viral haemorrhagic fevers, such as Marburg, Ebola and COVID-19 (1, 2). With the viral haemorrhagic fevers pandemics, the use of facemasks became a symbol of protection (3), and consistent use in the healthcare environment was advised in addition to other infection prevention and control (IPC) measures to reduce disease transmission (4, 5). When donned correctly, facemasks and respirators for respiratory aerosols provide a physical barrier between the mouth and nose of the user and the immediate environment, thereby protecting from airborne pathogen droplets, fomites and contaminants (2, 6, 7).
A facemask alone cannot provide adequate protection or source control even when used correctly. Other IPC measures include hand hygiene, physical distancing of at least one metre, avoiding touching one’s face, respiratory etiquette, adequate ventilation in indoor settings, testing, contact tracing, quarantine and isolation. The application of composite measures is critical to prevent human-to-human transmission of SARS-CoV-2.
There are single-use and reusable facemasks, subdivided into face covers and surgical masks, based on the particle size and intended use (7–9). Before the COVID-19 pandemic, facemasks were used by healthcare workers (HCWs) to control the spread of infectious diseases, such as Influenza, Ebola and Middle East Respiratory Syndrome (4), with a significant protective effect (OR = 0.84; 95% CI = 0.71–0.99), which was more pronounced when the intervention duration was more than 2 weeks (OR = 0.76; 95% CI = 0.66–0.88) (10).
Microorganisms on the skin and upper respiratory tract are transferred to the facemask whilst wearing or removing it or due to frequent manipulation (11). Bacterial contamination of the mask poses a significant risk when they are not used, removed or disposed of appropriately and can lead to hospital-acquired infections (12–14). Surgical masks were recommended for all HCWs, irrespective of their patients’ COVID-19 status (2). The guidance recommends that all HCWs and caregivers wear a medical mask during patient care (2). The control of SARS-CoV-2 infection amongst HCWs is associated with using surgical facemasks in the healthcare environment (15). However, the correct use, removal and disposal of facemasks are essential to ensure their effectiveness and avoid any risk of increased transmission (2).
HCWs are at reduced infection incidence of COVID-19 when facemask is used and removed as prescribed by the World Health Organisation (16, 17). Facemasks protect healthy HCWs and reduce the transmission of infectious agents from fomites and infected individuals to the population (2). Before using a surgical facemask, the guidelines recommend that users ensure the mask is not damaged, covers the mouth and nose, is adjusted to the nose bridge and tied securely, and avoid touching the mask whilst wearing (2).
Previous studies elsewhere reported poor compliance with WHO guidelines on facemask use, removal and disposal recommendations despite users’ good knowledge during the pandemic (18). The inappropriate use can increase the risk of infectious disease contamination and self-contamination amongst HCWs and the population (2). There is a lack of evidence on the level of awareness and compliance with the WHO and Nigeria’s National Centre for Disease Control (NCDC) guidelines, hence the need to ascertain the perception and practices of HCWs on the occupational use of surgical facemasks and identify and characterise the bacterial pathotypes in the study area.
This study ascertained compliance with and perceptions and practices regarding facemask use by HCWs with patients’ contact, characterised and isolated pathogenic pathotypes from occupationally used facemasks and explored the risk of occupational hazards and healthcare-associated infections amongst patients in the study area.
This study was conducted in a Federal Government-owned tertiary healthcare facility (HCF) with 26 wards. The study’s target population were HCWs with patient contacts (doctors, nurses, pharmacists, healthcare attendants, physiotherapists, dental assistants, laboratory technologists and scientists). In fulfilling its mandate, the tertiary HCF focuses on an integrated healthcare delivery approach emphasising comprehensive healthcare service to improve Nigerians’ physical, mental and socio-economic well-being through preventive, promotive, diagnostic, therapeutic and rehabilitative services.
This study utilised a descriptive cross-sectional design, and study data were collected between January and February 2022.
The sampling frame comprised medical doctors (n = 420), nurses (n = 540), health attendants (n = 210), pharmacists (n = 36), physiotherapists (n = 24) and laboratory scientists and technicians (n = 91). The HCWs with patient contact were selected by systematic sampling and enrolled in this study. At the same time, the administrative and eligible staff who were absent from work due to illness, injury and/or on official leave were excluded from the study.
Fisher’s formula for estimating a single proportion in cross-sectional studies was applied to determine the minimum sample size. The standard normal deviation was at a 95% confidence level, with prevalence at 88.75% (19) with an allowable margin of error of 5%. The calculated sample size was 153. The sample size was adjusted to 146, considering the total eligible population was 1,321 and less than 10,000 respondents. The minimum sample size was increased to 161 when adjusted for attrition or inappropriately filled questionnaires.
A stratified sampling technique was employed. The distribution of the HCWs with patient contact – doctors, nurses, laboratory scientists and health attendants – was determined using the information obtained from the hospital registry using the proportion-to-size method. The systematic sampling technique selected a representative and proportional sample from each stratum. The process of field data collection is described as follows:
The questionnaire was adapted from the study by Tadesse et al. (20) and refined with guides from the literature (21). The adapted questionnaire was subjected to face validity by an environmental health expert and two resident doctors (22). The questionnaire has four sections (A–D). Section A included questions on socio-demographic characteristics and wealth; Section B included questions on the perception of facemask use. Section C assessed the practice of facemask use, and Section D assessed the health hazards associated with mask use. The instrument was pretested in a tertiary HCF outside the study area.
The pretest administered 20 pieces of the data collection instrument to 20 HCWs (medical doctors, nurses, pharmacists, laboratory technologists and nursing assistants). The observations on the questions’ sequencing and participants’ difficulty in understanding some questions and similarly interpreted questions were addressed in plenary discussions, amended to reflect the pretest findings and finalised in English. The final draft of the instrument was administered to the study respondents in the study area.
The 2 mm × 2 mm of the nose and mouth area of the surgical facemasks were aseptically collected in Ziploc and transferred to the Laboratory. Each surgical facemask was cut with a sterilised scalpel, transferred into sterile bottles containing nutrient broth and incubated for about 24–48 h. The incubated organisms were inoculated (Fig. 1) into MacConkey Agar and further incubated for 12–24 h for growth. The growths observed were then gram-stained, the organisms were identified using the Microbact 12E kit, and the results were interpreted using the Microbact software (23).
Fig. 1. A petri dish showing microbial growth.
The antibiotic sensitivity (Fig. 2) was first achieved by inoculating the organisms into peptone water (standardised with the McFarland turbidity standard). Then, a diagnostic sensitivity test agar was prepared and flooded with the peptone water. The antibiotic disc was picked and placed aseptically into the agar, and incubation was done for another 12–24 h. After 24h, each dish was examined for the inhibition zones, and the antibiotic sensitivities were recorded.

Fig. 2. Antimicrobial sensitivity test.
Bacterial contamination of the facemask was assessed using colony-forming units (cfu/100 mL), bacterial isolation and culturing of facemask swabs. The swab specimen from each facemask was streaked into MacConkey and blood agar, and the bacterial load was determined by measuring the cfu/100 mL.
The questionnaires were manually sorted, cleaned and organised, and responses were entered according to the identity assigned to each facemask. The laboratory analytical data (the isolated bacteria and antibiotic resistance) were also entered into the corresponding serial IDs. The data were analysed using the IBM Statistical Package for Social Sciences (SPSS) version 29 software.
Frequency distribution tables and charts were used to describe the variables at the univariate level. Knowledge of respondents’ compliance with WHO guidelines in using facemasks was determined at the bivariate level with a p-value of <0.05. Wealth was a derived variable computed from the ownership or ownership of 21 household items. The predominant factor category through principal component analysis was applied to categorise respondents into poor, average and rich wealth groups (24).
Compliance was assessed using the five steps in the WHO recommendations on facemask use. A score of five was considered compliant, and less than five was non-compliant. The perception was assessed by a derived composite practice index that comprised 15 on facemask use. The median score was 12, and a score ≥12 was rated as a good perception and <12 as a poor perception. 14 questions were applied to determine practice, and the median score of 7 was used to dichotomise practice into good (≥7) and poor (<7) practice ratings. For all composite measure outcomes, correct responses were scored ‘1’, and incorrect responses were rated ‘0’.
This study showed that 61.5% (n = 99) of the HCWs were female, 70.8% (n = 114) were aged between 20 and 39 years, 56.5% (n = 91) had tertiary education, 64.0% (n = 103) had >5 years of work experience and 34.2% (n = 55) were classified as average in wealth status (Table 1). Amongst the respondents were 39.1% (n = 63) nurses, 31.7% (n = 51) medical doctors, 14.3% (n = 23) health attendants, 9.9% (n = 16) laboratory technicians, 2.5% (n = 4) pharmacists and 2.5% (n = 4) physiotherapists.
This study showed that 79.5% (n = 128) were aware of (1) sanitary hand disinfection before using a facemask and (2) covering the mouth and nose with a mask and ensuring there are no gaps between the face and the mask. Also, 77.0% (n = 124) knew about avoiding touching the mask whilst using it or cleaning hands with alcohol-based hand rub or soap and water if they do, and 80.7% (n = 130) were knowledgeable about replacing facemask with new ones when damp and non-reuse of single-use masks. 83.9% (n = 135) of the HCWs knew how to remove the facemask from behind and discard it immediately in a sanitary bin before cleaning their hands with alcohol-based disinfectants or soap and water. In summary, only 67.1% (n = 108) of HCWs had good knowledge level, whilst 32.9% (n = 33) exhibited poor knowledge of the WHO guidelines for using and removing soiled facemasks (Table 2).
In this study, 91.9% (n = 148) perceived that the use of a facemask prevents infectious diseases, 98.8% perceived that hand washing before and after facemask use prevents microbial contamination and 67.1% (n = 108) of HCWs thought that it is only necessary to wear a mask when one is infected with COVID-19; 85.7% thought that facemask only protects against COVID-19, whilst 91.3% (n = 147) thought that wearing a facemask frequently is one of the ways of reducing airborne infection. Additionally, 80.7% (n = 130) and 90.7% (n = 146) of respondents were aware of the correct steps in using a facemask and using a facemask protects against COVID-19 whilst on duty, respectively. 88.8% (n = 143) of the HCWs perceived that used facemasks should be disposed of sanitarily to protect against the transmission of viruses or other pathogens (Table 3). This study showed that 62.7% (n = 101) of HCWs had a good perception, whilst 37.3% (n = 60) had a poor perception rating.
This study showed that 2.5% (n = 4) of HCWs do not cover their nose and mouth appropriately when they wear facemasks, 1.2% (n = 2) do not wear a facemask at all times whilst on duty and 69.6% (n = 112) of HCWs pull down their facemasks to speak with clients/patients whilst on duty. Also, 31.7% (n = 51) always coughed or sneezed into their facemask, whilst 52.8% (n = 85) always changed facemasks when damp. In addition, 42.9% (n = 69) of HCWs do not wear facemasks for more than 4 h at a time (Table 4). As shown in Table 5, only 60.2% (n = 97) of HCWs reuse single-use facemasks, only 55.9% (n = 90) disinfect their hands before using facemasks and 47.2% (76) do not wash their hands after removing used facemasks. Additionally, 86.3% (n = 139) preferred single-use facemasks, whilst 13.7% (n = 22) preferred reusable facemasks. The composite practice index revealed that only 49.7% (n = 80) of HCWs had good practice, whilst 50.3% (n = 81) had poor practice.
The binary logistic regression showed that being married (0.032) and compliance with WHO guidelines on the use of facemasks (<0.001) were predictors of HCWs’ perception for the use of facemasks. Additionally, HCWs with tertiary education and postgraduate educational qualifications were about 5 and 12 times more likely to have a good perception of using facemasks (Table 6).
| Variables | B Coefficient | Odd ratio | 95% CI | P | |
| Lower | Upper | ||||
| Gender | |||||
| Male (Ref) | |||||
| Female | 0.124 | 1.132 | 0.393 | 3.263 | 0.818 |
| Highest education | 0.089 | ||||
| Secondary education (Ref) | |||||
| Tertiary education | 1.727 | 5.623 | 0.441 | 71.673 | 0.184 |
| Postgraduate education | 2.552 | 12.838 | 0.913 | 180.491 | 0.058 |
| Marital status | |||||
| Single (Ref) | |||||
| Married | -1.447 | 0.235 | 0.063 | 0.882 | 0.032* |
| Ethnicity | 0.493 | ||||
| Hausa(Ref) | |||||
| Igbo | -0.665 | 0.514 | 0.023 | 11.277 | 0.673 |
| Yoruba | -1.533 | 0.216 | 0.013 | 3.473 | 0.279 |
| Others | -1.726 | 0.178 | 0.005 | 6.660 | 0.350 |
| Religion | |||||
| Christianity (Ref) | |||||
| Islamic | 0.497 | 1.644 | 0.411 | 6.571 | 0.482 |
| Compliance with WHO guidelines | |||||
| No compliance (Ref) | |||||
| Compliance | 2.981 | 19.714 | 6.811 | 57.065 | <0.001* |
| Experience (years) | |||||
| 1–5 (Ref) | |||||
| >5 | 0.064 | 1.066 | 0.395 | 2.881 | 0.899 |
| Period of work daily (hours) | 0.966 | ||||
| 1–4 h (ref) | |||||
| 5–8 h | -0.250 | 0.779 | 0.119 | 5.081 | 0.794 |
| >8 h | -0.201 | 0.818 | 0.096 | 6.992 | 0.854 |
| Professions | 0.250 | ||||
| Doctor (Ref) | |||||
| Nurse | -0.373 | 0.689 | 0.198 | 2.395 | 0.557 |
| Health attendant | 0.119 | 1.126 | 0.224 | 5.672 | 0.886 |
| Pharmacist | -1.997 | 0.136 | 0.008 | 2.313 | 0.168 |
| Physiotherapist | -1.005 | 0.366 | 0.022 | 6.051 | 0.483 |
| Lab technician | 1.376 | 3.961 | 0.696 | 22.542 | 0.121 |
| Constant | -0.617 | 0.540 | 0.757 | ||
| Key: * = P < 0.05. | |||||
Similarly, the highest education (0.019) and postgraduate education (0.013) subset, in addition to nurse (0.031), health attendant (0.015) and laboratory technician (0.011) subsets of professions, were predictors of HCWs’ use of facemasks in practice. Additionally, HCWs who had tertiary education, postgraduate educational qualifications, Islamic religion, compliance with the WHO guidelines and laboratory technician vocation in healthcare facilities were about 5, 14, 1.6, 19.7 and 3.9 times more likely to exhibit good practice in the use of facemasks, respectively (Table 7).
| Variables | B Coefficient | Odd ratio | 95% CI | P | |
| Lower | Upper | ||||
| Gender | |||||
| Male (Ref) | |||||
| Female | 0.612 | 1.844 | 0.800 | 4.252 | 0.151 |
| Highest education | 0.019* | ||||
| Secondary education (Ref) | |||||
| Tertiary education | 1.790 | 5.988 | 0.815 | 43.997 | 0.079 |
| Postgraduate education | 2.662 | 14.324 | 1.756 | 116.846 | 0.013* |
| Marital status | |||||
| Single (Ref) | |||||
| Married | -0.301 | 0.740 | 0.285 | 1.921 | 0.536 |
| Ethnicity | 0.562 | ||||
| Hausa(Ref) | |||||
| Igbo | -0.102 | 0.903 | 0.066 | 12.398 | 0.939 |
| Yoruba | 0.071 | 1.073 | 0.102 | 11.314 | 0.953 |
| Others | 1.374 | 3.952 | 0.205 | 76.028 | 0.362 |
| Religion | |||||
| Christianity (Ref) | |||||
| Islamic | 0.671 | 1.956 | 0.660 | 5.804 | 0.226 |
| Compliance with WHO guidelines | |||||
| No compliance (Ref) | |||||
| Compliance | 0.251 | 1.286 | 0.579 | 2.855 | 0.537 |
| Experience (years) | |||||
| 1–5 (Ref) | |||||
| >5 | 0.364 | 1.439 | 0.629 | 3.294 | 0.389 |
| Period of work daily (hours) | 0.907 | ||||
| 1–4 h (Ref) | |||||
| 5–8 h | -0.014 | 0.986 | 0.223 | 4.361 | 0.985 |
| >8 h | 0.220 | 1.247 | 0.227 | 6.854 | 0.800 |
| Professions | 0.059 | ||||
| Doctor (Ref) | |||||
| Nurse | 1.105 | 3.018 | 1.108 | 8.217 | 0.031* |
| Health attendant | 1.690 | 5.418 | 1.385 | 21.195 | 0.015* |
| Pharmacist | 0.049 | 1.050 | 0.086 | 12.797 | 0.970 |
| Physiotherapist | -0.067 | 0.935 | 0.066 | 13.160 | 0.960 |
| Lab technician | 1.761 | 5.820 | 1.493 | 22.685 | 0.011* |
| Constant | -3.679 | 0.025 | 0.034 | ||
| Key: * = P < 0.05. | |||||
In this study, only 32 (25.6%) of the used facemasks collected (125) had growth when cultured, whilst 93 (74.4%) had no growth. Of the 32 used facemasks that had growth, the bacteria isolates identified were Enterobacter agglomerans (20, 62.5%), Proteus stuarti (9, 28.1%) and Morganella morganii (3, 9.4%).
Out of the 32 bacteria cultured, 18.8% were resistant to Ofloxacin, 96.9% were resistant to Augmentationin, 59.4% were resistant to Nitrofurantoin, 43.8% were resistant to Ciprofloxacin, 96.9% were resistant to Ceftazidime, 93.8% were resistant to Cefuroxime, 34.4% were resistant to Gentamicin and 87.5% were resistant to Cefixime (Fig. 3).

Fig. 3. Antimicrobial sensitivity tests.
The study’s findings revealed a significant proportion of females in the workforce who are relatively young and have higher educational qualifications. Also, the HCWs were predominantly nurses and doctors and economically advantaged. These are useful indicators for healthcare planning and policy development, bearing the associated brain drain in the studied workforce. Before the study, health education and promotional activities on the efficacy and the process for using and removing facemasks were coordinated by the NCDC in Nigeria. This was aimed at reducing the incidence of infectious disease morbidity and mortality amongst HCWs, especially the first responders in emergency wards. This included periodic interactive discussions, radio jingles, playlets and electronic and hard copies of promotional materials, including posters and leaflets, which were shared and aired at intervals in media houses.
Most of the respondents had a good perception of facemask use in contrast to poor practice on the use of facemasks in their workplaces, in congruence with studies with findings amongst university students in Vietnam (25), Nigeria amongst HCWs (19) and amongst Chinese university students (26). The increase in knowledge was associated with rigorous campaigns to promote compliance for using and removing facemasks amongst the population against COVID-19. However, this study’s findings were in contrast to those of Kumar et al. (27) in India and Tadesse et al. (20) in Ethiopia amongst HCWs, where positive attitudes and moderate to poor knowledge and practice were evident regarding the use of facemasks to prevent infectious disease transmission. However, the WHO recommends that all HCWs in healthcare facilities should wear facemasks continuously throughout the entire shift for potential protection from infectious diseases (4, 28). Besides, the logistics and non-supply of personal protective equipment consumables may also be responsible for poor practices, as there were limited supplies in the store at the time of the study.
Enterobacter agglomerans, Proteus stuarti and Morganella morganii were isolated and characterised from the used facemasks samples. Enterobacter agglomerans is a pathogenic gram-negative bacillus found in faeces, plants and soil. At the same time, Proteus stuarti is a pathogenic gram-negative bacillus found in water, soil and sewage, and Morganella morganii is a pathogenic gram-negative bacillus found in faeces. This revealed the possibility of cross-contamination of the facemasks by unwashed hands and the hospital environment, as these organisms are commonly associated with nosocomial infections. A similar study by Akpoka et al. (29) identified Peptococcus, Pseudomonas and Staphylococcus, which are also commonly associated with nosocomial infections. The microbes were attributed to the regular interaction resulting from coughing, talking and sneezing of HCWs and constant handling of hospital equipment (29). Besides, Delanghe et al. (11) identified Streptococcus and Staphylococcus spp. on used facemasks after 4 h of use (11). However, the difference in microbial isolates may be attributed to different study locations and diversity.
The microbial isolates showed various levels of resistance to Ofloxacin, Agmentin, Nitrofurantoin, Ciprofloxacin, Ceftazidime, Cefuroxime, Gentamicin and Cefixime, indicative of resistance to commonly used antimicrobial agents. This heightened the risk of nosocomial infections in HCWs, visitors and patients in healthcare facilities.
The one-time-use masks were initially designed to filter droplets that could potentially carry germs exhaled from the mouth and nose and protect the human respiratory system from microscopic airborne particles associated with respiratory conditions. The HCWs who complied with WHO guidelines on using, removing and disposing facemasks recorded no growths compared to the isolated microbes. This confirmed the potency of the guidelines in IPC of infectious and nosocomial infections in healthcare settings.
Handwashing at critical periods, irrespective of patient pressure, is also important in prevention, and the facilities are required to be provided at all points of care within healthcare facilities (30–33). The isolated organisms (Enterobacter agglomerans, Proteus stuarti, Morganella morganii) are all gram-negative enteric organisms that majorly follow the faecal route of transmission, are implicated as aetiological agents of nosocomial infection and are multi-drug resistant, which could significantly contribute to morbidity and mortality of HCWs.
The married status and compliance should be targeted to promote positive perception, perhaps because they are more likely to contract or transmit infections in HCFs and at home. The need to minimise overall risk has the increased potential for spreading infections to close family members and the need to protect their largely vulnerable populations. In addition, marriage status might be linked to specific behavioural patterns or lifestyle factors influencing infectious disease transmission. At the same time, the highest education, especially additional postgraduate education, nurses, health attendants and laboratory technicians, is predictors of the facemask use practice amongst HCWs and should strategically be focussed on promoting positive behaviour.
First, this study identified the need for HCWs to be educated on the use of facemasks, to follow WHO-recommended guidelines and to remove facemasks to prevent self-contamination and nosocomial infections. Second, this study identified pathogens resistant to antibiotics, which need to be monitored within healthcare facilities and the environment. Future research can be conducted to determine the inventory of facilities required by HCWs to comply with the IPC guidelines, including the use, removal and disposal of facemasks within the sociocultural barriers amongst HCWs in Nigeria.
The results showed that respondents with poor knowledge and no compliance with WHO guidelines on the use of facemask recorded a lower growth percentage (7.4%) than those with good knowledge and compliance (25.9%). It is essential to note that MacConkey agar, a selective and distinct bacterial culture medium designed to isolate Gram-negative and enteric bacteria preferentially, was employed in isolating these pathogens. This limited the study’s full scale and breadth and may have accounted for the ‘discordance’, as the cultured facemasks that yielded no growth may have borne other gram-positive and potentially more clinically relevant pathobionts, which would have been isolated.
Compliance with WHO guidelines for the use, removal and disposal of used facemasks is good in preventing infectious and nosocomial infections. Although most respondents have a good perception of the importance of using facemasks in occupational use, their practice could be improved. It needs to be improved since the bacterial isolates suggest inadequate hand hygiene. Therefore, knowledge about appropriate guidelines on the use, removal and safe disposal of used facemasks should be included in the training and continuous capacity building of HCWs to significantly decrease the risks associated with potential contamination and nosocomial infections.
The authors thank all the respondents who were part of this study and those who volunteered used facemasks despite the cultural dimensions of their release. We also appreciate the peer reviewers, who contributed immensely to shaping the manuscript.
Ethical permission (IPH/OAU/12/1898) was obtained from the Obafemi Awolowo University health ethics and research committe, and verbal consent was obtained from the respondent after a detailed explanation of the scope of the research. No harm was done to respondents, and the confidentiality of the information provided was assured.
The datasets used and analysed during the current study are available from the corresponding author upon reasonable request.
| 1. | Greenhalgh T, Schmid MB, Czypionka T, Bassler D, Gruer L. Face masks for the public during the covid-19 crisis. BMJ 2020; 369: m1435. doi: 10.1136/BMJ.M1435 |
| 2. | World Health Organization. Mask use in the context of COVID-19. 2020. Available from: https://www.ashrae.org/technical-resources/resources [accessed 4 Apr 2024]. |
| 3. | Goh Y, Tan BYQ, Bhartendu C, Ong JJY, Sharma VK. The face mask: how a real protection becomes a psychological symbol during Covid-19? Brain Behav Immun 2020; 88: 1–5. doi: 10.1016/J.BBI.2020.05.060 |
| 4. | MacIntyre CR, Chughtai AA. Facemasks for the prevention of infection in healthcare and community settings. BMJ 2015; 350: h694. doi: 10.1136/BMJ.H694 |
| 5. | NCDC. Infection prevention and control and confirmed cases of COVID-19. 2020, pp. 2–14. Available from: https://covid19.ncdc.gov.ng/guideline/%0A2 [cited 17 April 2022]. |
| 6. | Lepelletier D, Grandbastien B, Romano-Bertrand S, Aho S, Chidiac C, Géhanno JF, et al. What face mask for what use in the context of the COVID-19 pandemic? The French guidelines. J Hosp Infect 2020; 105(3): 414–18. doi: 10.1016/J.JHIN.2020.04.036 |
| 7. | FDA. N95 respirators, surgical masks, face masks, and barrier face coverings. Official U.S Government; 2021. Available from: https://www.fda.gov/medical-devices/personal-protective-equipment-infection-control/n95-respirators-surgical-masks-face-masks-and-barrier-face-coverings [cited 10 February 2022]. |
| 8. | European Union Aviation Safety Agency. What is meant by a ‘medical face mask’? European Union Aviation Safety Agency; 2021, p. 1. Available from: https://www.easa.europa.eu/faq/115286 [cited 10 February 2022]. |
| 9. | World Health Organization. Mask use in the context of COVID-19. World Health Organization; 2020, pp. 1–10. Available from: https://www.who.int/publications/i/item/advice-on-the-use-of-masks-in-the-community-during-home-care-and-in-healthcare-settings-in-the-context-of-the-novel-coronavirus-(2019-ncov)-outbreak [cited 10 February 2022]. |
| 10. | Li H, Yuan K, Sun Y-K, Zheng Y-B, Xu Y-Y, Su S-Z, et al. Efficacy and practice of facemask use in general population: a systematic review and meta-analysis. Transl Psychiatry. 2022; 12(49). doi: 10.1038/s41398-022-01814-3 |
| 11. | Delanghe L, Cauwenberghs E, Spacova I, De Boeck I, Van Beeck W, Pepermans K, et al. Cotton and surgical face masks in community settings: bacterial contamination and face mask hygiene. Front Med 2021; 8: 1477. doi: 10.3389/FMED.2021.732047/BIBTEX |
| 12. | Khan HA, Ahmad A, Mehboob R. Nosocomial infections and their control strategies. Asian Pac J Trop Biomed 2015; 5(7): 509–14. doi: 10.1016/J.APJTB.2015.05.001 |
| 13. | Luksamijarulkul P, Aiempradit N, Vatanasomboon P. Microbial contamination on used surgical masks among hospital personnel and microbial air quality in their working wards: a hospital in Bangkok. Oman Med J 2014; 29(5): 346. doi: 10.5001/OMJ.2014.92 |
| 14. | Pittet D, Allegranzi B, Storr J, Donaldson L. ‘Clean care is safer care’: the global patient safety challenge 2005–2006. Int J Infect Dis 2006; 10(6): 419–24. doi: 10.1016/J.IJID.2006.06.001 |
| 15. | Liao M, Liu H, Wang X, Hu X, Huang Y, Liu X, et al. A technical review of face mask wearing in preventing respiratory COVID-19 transmission. Curr Opin Colloid Interface Sci 2021; 52: 101417. doi: 10.1016/J.COCIS.2021.101417 |
| 16. | Lan F-Y, Christophi CA, Buley J, Iliaki E, Bruno-Murtha LA, Sayah AJ, et al. Effects of universal masking on Massachusetts healthcare workers’ COVID-19 incidence. Occup Med 2020; 70: 606–9. doi: 10.1093/occmed/kqaa179 |
| 17. | Romano-Bertrand S, Carré Y, Aho Glélé LS, Lepelletier D. How to address SARS-CoV-2 airborne transmission to ensure effective protection of healthcare workers? A review of the literature. Infect Dis Now 2021; 51(5): 410–17. doi: 10.1016/j.idnow.2021.05.005 |
| 18. | Lee LYK, Lam EPW, Chan CK, Chan SY, Chiu MK, Chong WH, et al. Practice and technique of using face mask amongst adults in the community: a cross-sectional descriptive study. BMC Public Health 2020; 20(1): 948. doi: 10.1186/S12889-020-09087-5 |
| 19. | Ejeh FE, Saidu AS, Owoicho S, Maurice NA, Jauro S, Madukaji L, et al. Knowledge, attitude, and practice among healthcare workers towards COVID-19 outbreak in Nigeria. Heliyon 2020; 6(11): e05557. doi: 10.1016/J.HELIYON.2020.E05557 |
| 20. | Tadesse T, Tesfaye T, Alemu T, Haileselassie W. Healthcare worker’s knowledge, attitude, and practice of proper face mask utilization, and associated factors in police health facilities of Addis Ababa, Ethiopia. J Multidiscip Healthc 2020; 13: 1203. doi: 10.2147/JMDH.S277133 |
| 21. | Aluko OO, Adebayo AE, Adebisi TF, Ewegbemi MK, Abidoye AT, Popoola BF. Knowledge, attitudes and perceptions of occupational hazards and safety practices in Nigerian healthcare workers. BMC Res Notes 2016; 9(1): 71. doi: 10.1186/S13104-016-1880-2 |
| 22. | Bolarinwa O. Principles and methods of validity and reliability testing of questionnaires used in social and health science researches. Niger Postgrad Med J 2015; 22(4): 195. doi: 10.4103/1117-1936.173959 |
| 23. | Khan LB, Swift S, Kamal T, Read HM. Simulation of MICROBACT strip assay using colored liquids to demonstrate identification of unknown gram-negative organisms in undergraduate laboratory. J Microbiol Biol Educ 2018; 19(2): 19.2.76. doi: 10.1128/jmbe.v19i2.1565 |
| 24. | Aluko OO, Udechukwu JN, Arowosafe PO, Loto OA, Ojogba GO, Orisawayi O, et al. Attitudes Towards Menstrual Health by Female In-School Adolescents: A Comparative Cross-Sectional Study in Southwest Nigeria. Women’s Reproductive Health. 2023. Available from: https://www.tandfonline.com/doi/abs/10.1080/23293691.2023.2287528 [cited 16 April 2024]. |
| 25. | Duong MC, Nguyen HT, Duong BT. A cross-sectional study of knowledge, attitude, and practice towards face mask use amid the COVID-19 pandemic amongst university students in Vietnam. J Community Health 2021; 46(5): 975–81. doi: 10.1007/s10900-021-00981-6 |
| 26. | Peng Y, Pei C, Zheng Y, Wang J, Zhang K, Zheng Z, et al. A cross-sectional survey of knowledge, attitude and practice associated with COVID-19 among undergraduate students in China. BMC Public Health 2020; 20(1): 1292. doi: 10.1186/s12889-020-09392-z |
| 27. | Kumar J, Katto MS, Siddiqui AA, Sahito B, Jamil M, Rasheed N, et al. Knowledge, attitude, and practices of healthcare workers regarding the use of face mask to limit the spread of the new coronavirus disease (COVID-19). Cureus 2020; 12(4): e7737. doi: 10.7759/cureus.7737 |
| 28. | WHO. Infection prevention and control assessment framework at the facility level. Introd User Instruct 2018; 2016: 1–15. Available from: http://www.who.int/infection-prevention/ [cited 12 May 2020]. |
| 29. | Akpoka OA, Enaigbe AA, Irodi CC. Bacterial contaminations of used face masks collected from different clinical sections in a university teaching hospital during Covid-19 pandemic crises in Nigeria. Bacter Emp 2021; 4(1): 8–10. doi: 10.36547/be.2021.4.1.8-10 |
| 30. | Brauer M, Zhao JT, Bennitt FB, Stanaway JD. Global access to handwashing: implications for COVID-19 control in low-income countries. Environ Health Perspect 2020; 128(5): 057005. doi: 10.1289/ehp7200 |
| 31. | Alzyood M, Jackson D, Aveyard H, Brooke J. COVID-19 reinforces the importance of handwashing. J Clin Nurs 2020; 29(15–16): 2760–1. Available from: https://www.ncbi.nlm.nih.gov/pmc/articles/PMC7267118/ [cited 31 August 2020]. |
| 32. | Wodnik B, Freeman M, Ellis A, Awino Ogutu E, Webb Girard A, Caruso B. Development and application of novel caregiver hygiene behavior measures relating to food preparation, handwashing, and play environments in rural Kenya. Int J Environ Res Public Health 2018; 15(9): 1994. doi: 10.3390/ijerph15091994 |
| 33. | Burton M, Cobb E, Donachie P, Judah G, Curtis V, Schmidt WP. The effect of handwashing with water or soap on bacterial contamination of hands. Int J Environ Res Public Health 2011; 8(1): 97–104. doi: 10.3390/ijerph8010097 |